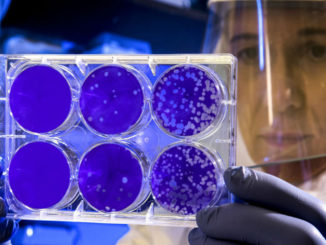

Tamponi, tracciamento e hot-spot: il Piemonte si prepara per l’autunno
Accurata attività di ricerca attiva dei casi con tamponi ai contatti stretti asintomatici, sorveglianza attiva sul personale di enti pubblici e privati, incremento degli “hot spot” pediatrici. […]